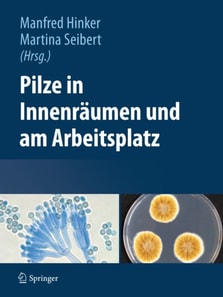
Pilze in Innenräumen und am Arbeitsplatz

Pilze in Innenräumen und am Arbeitsplatz
Dieses Buch geht der Frage nach, welche Rolle Pilze in der Arbeitswelt spielen, wie sie detektiert und identifiziert werden und welche gesundheitliche Bedeutung sie für den Menschen haben. „Unbeabsichtigt“ treten wir mit Schimmelpilzen zum Beispiel in Gebäuden, in der Landwirtschaft, der Abfallentsorgung und der metallverarbeitenden Industrie in Kontakt. Die „beabsichtigte Verwendung“ reicht von d...
Dieses Buch geht der Frage nach, welche Rolle Pilze in der Arbeitswelt spielen, wie sie detektiert und identifiziert werden und welche gesundheitliche Bedeutung sie für den Menschen haben. „Unbeabsichtigt“ treten wir mit Schimmelpilzen zum Beispiel in Gebäuden, in der Landwirtschaft, der Abfallentsorgung und der metallverarbeitenden Industrie in Kontakt. Die „beabsichtigte Verwendung“ reicht von d...